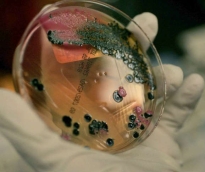
alsharq

تتجه أنظار عشاق كرة القدم حول العالم إلى أمريكا الشمالية، التي تستضيف كأس العالم 2026، النسخة الأكبر والأكثر استثنائية في تاريخ البطولة. ولأول...
رئيس مجلس الإدارة : د. خالد بن ثاني آل ثاني

رئيس التحرير: جابر سالم الحرمي

مساحة إعلانية

تسبب الزلزال الذي ضرب ولاية كاليفورينا الأميركية، في وقت مبكر من صباح أمس، وبلغت قوته 6 درجات على مقياس ريختر، في إثارة الذعر بين السكان، حيث تذكر عدد كبير منهم زلزال 1989. كما أحدث أضرارا بعدد من المباني التاريخية، والمباني التجارية والمنازل، وتبعه انقطاع للتيار الكهربائي في عدة مناطق من مدينة "نابا"، التي كانت الأكثر تضررا في الولاية. وأعلنت السلطات عدم تسجيل حالات وفاة بسبب الزلزال، وإصابة 90 شخصاً، بينهم 3 في حالة خطيرة. ولحق الزلزال أضرار بعدد من المباني، والواجهات الزجاجية المهشمة للمحال التجارية، حيث تساقطت بضائعها من على الرفوف، كما استمع من الأهالي لما شعروا به لحظة وقوع الزلزال. وأفادت "جين لاثوم" بأنها كانت نائمة عند حدوث الزلزال، واستيقظت وهي تصرخ، في حين كانت ابنتها مستيقظة وسمعت صوت أزيز قبل وقوع الزلزال، مضيفة "كانت الاهتزازات قوية ومخيفة جدا". بدورها قالت، "دينا شيكوفا"، "خفت كثيرا، أخذ كلبي في النباح بشدة قبل حدوث الزلزال محاولا إيقاظي". أما "رودي يلدز"، الذي يمتلك مطعما في المدينة، فقد كان نائما هو الآخر عند حدوث الزلزال، واستيقظ مرعوبا دون أن يفهم ما يحدث، حيث كان كل شيء يهتز على خلفية من الأصوات الغريبة وانقطاع التيار الكهربائي، ما جعله ينتظر تهاوي جدران المنزل عليه في أي لحظة. وبعد تجاوز الصدمة الأولى هرع يلدز للاطمئنان على أطفاله، وعندما وجدهم بخير توجه إلى المطعم حيث اكتشف تعرض بنائه الأثري لبعض الأضرار. وختم يلدز حديثه بالتعبير عن سعادته لعدم تسبب الزلزال في حدوث خسائر في الأرواح. واستيقظت "أندريا جريجو" قبل 5 دقائق من حدوث الزلزال على مكالمة من أحد أصدقائها، وعندما حدث الزلزال نهضت بسرعة، ما تسبب في إصابتها إصابة خفيفة، وعندما حاولت الخروج من الحجرة وجدت أن الباب قد علق ولم يعد بإمكانها فتحه. وتصف أندريا ما شعرت به في تلك اللحظات قائلة "لقد كان مخيفا جدا، كنت هنا عندما حدث زلزال 1989، إلا أن هذا الزلزال مختلف، كانت هناك الكثير من الأصوات".
317
| 24 أغسطس 2014

قالت هيئة المسح الجيولوجي الأمريكية: إن زلزالا بقوة 6 درجات ريختر وقع في ولاية كاليفورنيا في وقت مبكر اليوم الأحد. وأضافت أن مركز الزلزال كان على بعد 8 كيلو مترات شمال غربي بلدة أمريكان كانيون، ولم ترد بعد أنباء عن وقوع خسائر.
243
| 24 أغسطس 2014

عرقل مئات الأشخاص من النشطاء والمحتجين، اقتراب إحدى السفن الإسرائيلية، من أحد الموانئ الأمريكية بولاية كاليفورنيا، لتفريغ حملتها. المحتجين نجحوا في منع سفينة تابعة لشركة "زيم" وهى شركة شحن إسرائيلية، من الاقتراب من ميناء "لونغ بيتش" بولاية كاليفورنيا غربي الولايات المتحدة.
271
| 24 أغسطس 2014

قررت شركة "فيراري" أن تطلق موديلها الرياضي الجديد بلا سقف 458 والتي أضيف إلى لقبها كلمة سبايدر احتفالاً بسقفها المكشوف. وقالت صحيفة "4 ويلز نيوز" إن الكشف عن الموديل الجديد سيتم في معرض "مسابقة الأناقة" الذي سيقام في مدينة بابل بيتش بولاية كاليفورنيا الأمريكية. ويجب أن يصبح الموديل الجديد أسرع سيارة للشركة إلى أن تطلق سيارة سوبر جديدة " La Ferrari Spider ". وسيتزود الموديل بمحرك " V8 " سعة 4.5 لتر يولد قوة 605 أحصنة و 540 نيوتن على متر لعزم الدوران . وتتسارع السيارة حتى سرعة 200 كلم في الساعة خلال 9.1 ثانية.
692
| 20 أغسطس 2014

قالت وسائل إعلام أمريكية، إن هرا غاضبا حاصر امرأة وابنتها في غرفة نومهما في كاليفورنيا لساعات طويلة قبل أن يضطرا للاتصال بالشرطة لإخراج القط من المنزل. وذكرت قناة كي.جيه.تي.في التلفزيونية إن المرأة وابنتها البالغة اتصلتا بالسلطات بعد أن ظل الهر "كوبي" يهاجمهما كلما همتا بالخروج من الغرفة. وقالت جارتهما كارين يارجر للقناة التلفزيونية وهي تقف خارج منزلها في مقاطعة سان دييجو "تحول (الهر) إلى كرة من الغضب". وأشارت القناة، إلى أن الهر كوبي كان مع الأسرة منذ 14 عاما. وأضافت أن مثل هذه الاتصالات طلبا للنجدة يتم التعامل معها بشكل معتاد وأن ضباطا من إدارة شرطة تشولا فيستا كانوا بالمنطقة وتمكنوا من المساعدة في إخراج القط إلى حديقة المنزل.
1065
| 15 أغسطس 2014
قالت المراكز الأمريكية لمكافحة الأمراض والوقاية منها، يوم أمس الخميس، إن تفشيا لبكتريا السالمونيلا مرتبطا بدواجن ملوثة لشركة منتجة في كاليفورنيا انتهى على ما يبدو بعد أكثر من 17 شهرا على ظهوره. وقالت المراكز إن تفشي سالمونيلا هايدلبرج -الذي يقول مفتشون للصحة العامة إنه بدأ في مارس اذار من عام 2013 وانتهى في 11 من يوليو تموز الماضي- أصاب 634 شخصا في 29 ولاية أمريكية. وحدد علماء سبع سلالات من بكتريا السالمونيلا أثناء انتشار المرض، وكان يعد هذه السلالات مقاوما للمضادات الحيوية المستخدمة في علاج المصابين. وقالت المراكز الأمريكية، "أظهرت التحقيقات الوبائية والمختبرية وتحقيقات التقصي التي أجراها مسؤولون محليون واتحاديون أن تناول دواجن من إنتاج مزارع فوستر كان مصدر الإصابات ببكتريا سالمونيلا هايدلبرج". ولم تسجل اي وفيات بسبب المرض. وقال محققون، إن 38% من الحالات المسجلة تلقوا علاجا بالمستشفيات وهو معدل مرتفع بالنسبة لهذا النوع من السالمونيلا. وكانت شركة مزارع فوستر قالت العام الماضي إنها بدأت برنامجا جديدا لسلامة الغذاء قيمته 75 مليون دولار للحد من تلوث منتجاتها ببكتريا السالمونيلا.
744
| 01 أغسطس 2014

ينتشر حريقان ضخمان بسرعة كبيرة في ولاية كاليفورنيا الامريكية مما قد يجبر المئات من السكان على ترك مساكنهم المهددة، حسبما افاد مسؤولون امريكيون. ففي المنطقة المحيطة بمدينة ساكرامنتو، انتشرت الحرائق بحيث تجاوزت المساحة التي تلتهمها 2000 هكتارا، فيما ينتشر حريق آخر بالقرب من محمية يوسيميتي الطبيعية. ويقول مسؤولون محليون إن فرق الإطفاء لم تتمكن من السيطرة إلا على 20% من حريق ساكرامنتو. يذكر أن الجفاف الذي تعاني منه ولاية كاليفورنيا، قد تسبب في اندلاع عدد أكبر من الحرائق هذا العام، إذ شهدت الولاية اندلاع 1400 حريقا وهو ضعف العدد الذي تشهده في العادة. ونقلت صحيفة لوس أنجلوس تايمز، عن مسئولين محليين في ساكرامنتو قولهم إن مساحة الحرائق قد تضاعفت منذ اندلاعها عصر الجمعة، مما أجبر 515 عائلة على إخلاء مساكنها. ويشارك في جهود احتواء الحرائق نحو 1500 من رجال الإطفاء تساندهم طائرة صهريج.
351
| 28 يوليو 2014

قررت ولاية كاليفورنيا الأمريكية، المطلة على الساحل الغربي للولايات المتحدة، اتخاذ إجراءات لتوفير المياه بسبب الجفاف الشديد المستمر منذ فترة طويلة في. وبحسب قرار اللجنة الحكومية المختصة بشؤون المياه، أمس الثلاثاء، لن يسمح لسكان الولاية، اعتبارا من أغسطس المقبل، برش الأرصفة والمداخل بخرطوم الري أو ملء النافورات بمياه الشرب أو ري المساحات الخضراء بمياه زائدة على الحد، كما يتعين أن تكون الخراطيم المستخدمة في غسل السيارات مزودة بصمامات إغلاق. وقررت اللجنة فرض غرامات على المخالفين للوائح الجديدة، قد تصل إلى 500 دولار في اليوم. ووفقا لبيان اللجنة، فإن استهلاك معظم سكان كاليفورنيا من المياه يزيد خارج المنزل، مثل ري حدائق المنازل، وذكرت اللجنة أن اللوائح الجديدة تهدف إلى إلزام السكان بإجراءات تقشفية أكبر في استهلاك المياه.
748
| 16 يوليو 2014

تم اكتشاف حفريات في موقع بناء في وادي السليكون، مركز أعمال التكنولوجيا المتقدمة في ولاية كاليفورنيا، يعتقد أنها تعود لــ20 مليون سنة مضت، حسبما ذكرت صحيفة "سان خوسيه ميركوري نيوز"، أمس الاثنين. وقالت الصحيفة، إن من بين الآثار الطبيعية المكتشفة أسنانا لسمكة قرش طولها 10 أمتار وأسنانا لمخلوق منقرض يشبه فرس النهر و9 جماجم لحيتان ونوعين من المحار. واكتشفت الحفريات من قبل عمال بناء يشيدون سدا يبلغ ارتفاعه 66 مترا في خزان كالافيراس بالقرب من مقار العديد من أكبر شركات التكنولوجيا في العالم والآلاف من الشركات الناشئة الصغيرة بشمال كاليفورنيا. وحتى الآن تم اكتشاف أكثر من 500 حفرية تعود للعصر الميوسيني في الموقع منذ عام 2011 عندما بدأت أعمال البناء.
269
| 08 يوليو 2014

قال علماء من أمريكا، إنهم عثروا على تفسير محتمل لوجود مسارات مختلفة لمرض ألتسهايمر "الزهايمر" مما يصعب تطوير عقاقير مناسبة للتداوي منه. وحسب الباحثين تحت إشراف ستانلي بروسينر من جامعة كاليفورنيا، بمدينة سان فرانسيسكو، في دراستهم التي نشرت نتائجها، اليوم الثلاثاء، في مجلة "بروسيدنجز" التابعة للأكاديمية الأمريكية للعلوم، فإن هناك على الأقل سلالتين مختلفتين للبروتين الذي يؤدي للإصابة بالمرض. يشار إلى أن الطبيب بروسينر حصل عام 1997 على جائزة نوبل للطب على اكتشافه ما يسمى بالبريونات. ومشيرا لنتائج الدراسة قال بروسينر"يمكن أن تساعد النتائج التي توصلنا إليها في شرح كيفية نشأة مرض ألتسهايمر على مستوى الجزيئات وتطوير عقاقير مضادة لبريونات أميلويد بيتا". ومن المعروف أن أميلويد بيتا هو بروتين ينشأ خلال عملية الأيض ولكنه عادة ما يتحلل، وتتراكم أحماض أميلويد بيتا المصابة بكميات كبيرة في المخ وتدمر الخلايا العصبية بشكل تدريجي وناقل لعدوى الأحماض المصابة، مما يجعل الإصابات تنتقل لأحماض أميلويد بيتا السليمة، حسبما أكد الباحثون.
286
| 01 يوليو 2014

قال نائب لرئيس شرطة مقاطعة لوس أنجلوس في كاليفورنيا، إن ابن الممثل روبرت داوني، ألقي القبض عليه للاشتباه في حيازته مخدرات في ويست هوليوود. وقال السارجنت ديف فالانتين، إن أنديو فالكونر داوني "20 عاما" ابن الممثل الشهير الذي شارك في فيلم "الرجل الحديدي" قبض عليه بعد ظهر يوم الأحد، ومعه ما تعتقد السلطات أنه كوكايين وأنبوب يستخدم في تدخينه. وقال فالانتين إنه تم إلقاء القبض على داوني، بعد أن استوقفت الشرطة السيارة التي كان مسافرا بها، ولم تقبض الشرطة على أحد آخر في السيارة. وسدد داوني كفالة مالية 10250 دولارا، وتم إطلاق سراحه بعد منتصف الليل بوقت قصير بالتوقيت المحلي، وحدد له موعد للمثول أمام المحكمة في 29 من أغسطس.
1067
| 01 يوليو 2014

انطلق من برج إطلاق في قاعدة لإطلاق الصواريخ تابعة للبحرية الأمريكية، في كاواي، بولاية هاواي، بالمحيط الهادي، أمس السبت، منطاد ضخم يحمل مركبة فضاء تجريبية على شكل صحن، تابعة لإدارة الفضاء والطيران الأمريكية "ناسا"، لاختبار أنظمة الهبوط للمركبة التي سترسلها ناسا في مهام لكوكب المريخ في المستقبل. ولكن التجربة فشلت بسبب تعثر انتفاخ مظلة ضخمة، كانت تهدف إلى قيادة المركبة للهبوط في المحيط الهادي بشكل سليم. وقال دان كواتا، المهندس بناسا في معمل الدفع النفاث في باسادينا بولاية كاليفورنيا، خلال مقابلة على تلفزيون ناسا "هذه فرصة بالنسبة لنا لمراجعة البيانات، والتعلم مما حدث وتطبيق ذلك على التجربة التالية". وكان المنطاد الذي يعمل بالهليوم قد انطلق الساعة 2.40 بعد ظهر، أمس السبت، بتوقيت شرق الولايات المتحدة، ووصل إلى ارتفاعه المستهدف الذي بلغ 120 ألف قدم "36576 مترا" فوق المحيط الهادي بعد ذلك بنحو ساعتين ونصف.
285
| 29 يونيو 2014

ذكرت تقارير إخبارية اليوم الاثنين، أن النجم الأمريكي جورج كلوني يفكر حاليا في الترشح لمنصب حاكم ولاية كاليفورنيا عن الحزب الديمقراطي، وذلك في الانتخابات التي ستجرى عام 2018، ليحذو بذلك حذو النجم أرنولد شوارزينجر. وأفادت صحيفة "ديلي ميرور" البريطانية نقلا عن أحد المصادر قوله إن "جورج يتمتع بشعبية كبيرة بين الديمقراطيين، وإنه أنسب شخص لمنصب حاكم كاليفورنيا، موطن هوليوود". وكانت تقارير أفادت مؤخرا بأن جورج سيبدأ العمل السياسي بعد زواجه من خطيبته المحامية البريطانية من أصل لبناني آمال علم الدين في سبتمبر المقبل، حيث رفض أخيرا عددا من المشاريع السينمائية لكي يتفرغ لخوض الانتخابات وشغل المنصب وللعمل السياسي. وأشارت الصحيفة إلى أن آمال (36 عاما) التي تعمل في مجال الدفاع عن حقوق الإنسان في لندن، يقال إنها متحمسة للاستمرار في عملها في العاصمة البريطانية إلا أنها ستفكر في الانتقال للولايات المتحدة لدعم كلوني (53 عاما).
314
| 16 يونيو 2014

قالت متحدثة باسم قيادة الدفاع الجوي لأمريكا الشمالية، أمس الخميس، إن قاذفتين روسيتين بعيدتي المدى تم رصدهما أثناء تحليقهما على مبعدة 50 ميلا فقط من ساحل كاليفورنيا في وقت سابق هذا الأسبوع، وان مسؤولي الدفاع الجوي أرسلوا مقاتلتين إف-22 للتحقق بصريا من هويتهما. وأضافت الميجر بيث سميت، أن القاذفتين الروسيتين لم تدخلا مطلقا المجال الجوي للولايات المتحدة أثناء ما بدا أنها مهمة تدريبية روتينية. وقالت سميث، إن 4 قاذفات روسية من نوع تي يو-95 وهي قاذفات إستراتيجية بعيدة المدى ترافقها طائرة صهريج للتزويد بالوقود في الجو تم رصدها أولا وهي تدخل ما يطلق عليه منطقة الدفاع الجوي لتحديد الهوية "أديز" التي تمتد لمسافة 200 ميل من ساحل آلاسكا يوم الإثنين. وأضافت، إن القاذفات غادرت المنطقة متجهة غربا بعد أقامت مقاتلتان إف-22 انطلقتا من منطقة نوراد في آلاسكا اتصالا بصريا معها. وقالت سميث إنه بعد ذلك بـ5 ساعات تم رصد اثنتان من القاذفات الروسية على مبعدة 50 ميلا من ساحل كاليفورنيا وقامت مقاتلتان إف-15 أمريكيتان بالتحقق منهما بصريا.
303
| 13 يونيو 2014

ذكرت تقارير إخبارية، اليوم الثلاثاء، أن شركة خدمات الإنترنت الأمريكية العملاقة جوجل، استحوذت على شركة سكاي بوكس للتصوير بالأقمار الصناعية مقابل 500 مليون دولار، بهدف تعزيز خدمات خرائط جوجل وتحسين الاتصال بالإنترنت. وذكرت جوجل الموجودة في منطقة ماونتن فيو، بولاية كاليفورنيا الأمريكية أنها ستسدد قيمة الصفقة نقدا بالكامل. تعمل سكاي بوكس، في مجال تصميم الأقمار الصناعية لالتقاط الصور بتفاصيل دقيقة حيث يتم تصويرها بتقريب يقل عن متر واحد ثم إرسالها للعملاء. وأضافت جوجل عبر موقعها الإلكتروني، أن "أقمار سكاي بوكس الصناعية ستساعد جوجل مابس (خدمة الخرائط) في توفير صور مباشرة بتفاصيل دقيقة.. بمرور الوقت نأمل أيضا أن يتمكن فريق سكاي بوكس وتقنياتها من المساعدة في تحسين الاتصال بالإنترنت والمساهمة في عمليات الإغاثة في حالات الكوارث وهي المجالات التي تهتم بها جوجل منذ وقت طويل". وذكرت وكالة بلومبرج للأنباء الاقتصادية، أن جوجل تسعى إلى عقد مثل هذه الاتفاقيات لكي تدخل إلى أسواق جديدة وتعزز خدماتها التقليدية مثل خدمة الخرائط ومحرك البحث. كما تبحث الشركة عن طرق جديدة لتوفير خدماتها الإلكترونية للمستخدمين من خلال "مشروع لون" الذي كشفت عنه العام الماضي لمساعدة الذين يعيشون في المناطق الريفية والمناطق النائية للاتصال بالإنترنت باستخدام البالون وغيره من الآلات.
436
| 10 يونيو 2014

كشفت شركة الإلكترونيات الأمريكية آبل، عن أنظمة تشغيل جديدة لأجهزة الكمبيوتر الشخصي "ماك" والهواتف الذكية "آي فون" والكمبيوتر اللوحي "آي باد". وذكرت "آبل" في بيان لها, أن النظام الجديد يحمل اسم "أو.إس إكس" واسم الشهرة "يوسي مايت" نسبة للمتنزه الشهير في ولاية كاليفورنيا.. ومن المقرر طرحه في الأسواق مجانا في الخريف المقبل حيث يتميز بتصميم أفضل وتقديم نتائج بحث أفضل تضاهي بطاقات المعلومات التي تقدمها نتائج بحث خدمة "جوجل ناو", ويدمج نظام التشغيل الجديد بين أجهزة آبل المختلفة حيث يتيح تحويل المستخدم من جهاز إلى آخر بصورة سلسة. وأضافت "آبل" أن لديها سجل يضم حوالي 80 مليون مستخدم على منصات ماك. يذكر أن نظام التشغيل الجديد "آي.أو.إس 8" يستخدم مع أجهزة "آي باد وآي فون" حيث يتيح قدرة أفضل على تبادل المعلومات التفاعلية ويتيح للمستخدم الرد على الرسائل مباشرة من شاشاتهم المغلقة. وأوضح تيم كوك، الرئيس التنفيذي لشركة "آبل" إن الشركة باعت الآن أكثر من 800 مليون جهاز يعمل بنظام التشغيل "آي.أو.إس" منها 500 مليون جهاز "آي فون".
324
| 03 يونيو 2014

وصل عدد القطط في مأوى منزل الأمريكية لينيا لاتانزيو بولاية كاليفورنيا، إلى ما يقرب من 24 ألف قطة، لتحصل على لقب صاحبة أكبر مأوى للقطط في العالم. وأنشأت لاتانزيو المأوى في 1992، معتمدة على التبرعات، بهدف إنقاذ القطط المشردة ومعالجتها من المشاكل الصحية والمشاكل السلوكية. بحسب ما جاء في موقع "بورد باندا".
328
| 01 يونيو 2014

اشترت الممثلة البريطانية، إيميلي بلانت، وزوجها الممثل الأميركي، جون كراسينسكي، منزلاً في غرب تلال هوليوود بأكثر من 2.5 مليون دولار. وأفادت صحيفة لوس أنجلس تايمز الأميركية أن بلانت وكراسينسكي دفعا 2.575 مليون دولار مقابل منزل فخم في غرب تلال هوليوود بكاليفورنيا. ولفت إلى أن هذا المنزل بني في العام 1965، وهو يحتوي على حوض سباحة كبير و4 غرف نوم و4 حمامات ومكتب. يشار إلى ان الزوجين، اللذين رزقا بطفلتهما الأولى هايز في فبراير الماضي، سبق أن اشتريا قبل فترة قصيرة منزلاً آخر في اوجاي بكاليفورنيا أيضاً.
377
| 31 مايو 2014

قالت الشرطة أمس الأربعاء، إن امراة خطفت في منزلها في جنوب كاليفورنيا عندما كان عمرها 15 عاما، عثر عليها حية بعد محنة استمرت عشر سنوات، تعرضت خلالها للاعتداء الجسدي والجنسي. وقالت شرطة سانتا آنا في بيان، إن المرأة وعمرها 25 عاما الآن، أبلغت المحققين أنها خطفت في أغسطس 2004 على يدي رجل كان يعيش مع أسرتها آنذاك، وأنه ظل يحتجزها طيلة هذه السنوات. وحجبت السلطات اسم المرأة، وقالت الشرطة إن الخاطف اعتدى جنسيا على الضحية في أثناء مدة الخطف وأنها أنجبت طفلا عام 2012. وأضافت الشرطة أن المرأة اتصلت بالشرطة يوم الثلاثاء، بعدما تعرفت في بادئ الأمر على أخت لها عبر موقع فيسبوك للتواصل الاجتماعي. وقال الشرطة في البيان إنها ألقت القبض على إسيدرو جارسيا (41 عاما) يوم الثلاثاء في منزل عاش فيه مع المرأة في مدينة بيل جاردينز، للاشتباه في قيامه بخطف واغتصاب المرأة.
385
| 22 مايو 2014

واجه مئات من رجال الإطفاء سلسلة من حرائق الغابات جنوب كاليفورنيا اليوم الخميس، التي اشتعلت في 30 منزلا على الأقل وأجبرت السلطات على إخلاء محطة توليد الطاقة النووية في سان أونوفري من العاملين بها. ووفقا لـ كال فاير، الهيئة الحكومية لمكافحة الحرائق، أن الحرائق التي تغذيها الرياح قضت على أكثر من 3600 هكتار منذ اشتعالها أمس الأربعاء، بسبب ارتفاع درجة الحرارة بمعدل قياسي في وقت مبكر من السنة. وتصاعدت سحب هائلة من الدخان الأسود فوق أجزاء كبيرة من مقاطعة سان دييجو، حيث تشتعل أسوأ الحرائق اليوم، مدفوعة برياح سانتا آنا الحارة التي تجلب كميات كبيرة من الغبار معها من الصحراء. وقال دانيال برلنت المتحدث باسم"كال فاير" في مؤتمر صحفي: "في مقاطعة سان دييجو، شهدنا خلال الأيام الماضية ارتفاع درجات الحرارة وانخفاض معدلات الرطوبة وهبوب رياح قويةـ، هذا نمط الطقس الذي نراه عادة في فصل الخريف".
407
| 15 مايو 2014
مساحة إعلانية
الأكثر مشاهدة

نشرت الجريدة الرسمية، في عددها رقم (9) لسنة 2026 الصادر عن وزارة العدل، قرار وزير الدولة لشؤون الدفاع رقم (5) لسنة 2026 بشأن...
124514
| 07 يونيو 2026

انضم مهندس عربي في الكويت إلى قوائم أوائل المبعدين لتجاوز حدود السرعة لأكثر من 150 كم/س، وأحيل إلى إدارة الإبعاد. ونقلت صحيفة الأنباء...
109952
| 06 يونيو 2026

نشرت الجريدة الرسمية في عددها التاسع لسنة 2026 الصادر اليوم الأحد، قرار وزير التربية والتعليم والتعليم العالي رقم (6) لسنة 2026 بإنشاء أقسام...
23134
| 07 يونيو 2026

حمل تطبيق الشرق
تابع الأخبار المحلية والعالمية من خلال تطبيقات الجوال المتاحة على متجر جوجل ومتجر آبل
الأكثر رواجاً
- 1 بقرار رئيس ديوان الخدمة المدنية.. إليك الدورات المقررة للموظفين القطريين المرشحين للترقية
نشرت الجريدة الرسمية، في عددها رقم (9) لسنة 2026 الصادر عن وزارة العدل، قرار قرار رئيس ديوان الخدمة المدنية والتطوير الحكومي رقم (11)...
20406
| 07 يونيو 2026
- 2 بينها واشنطن و5 عواصم عربية.. إليك أحدث عروض القطرية على تذاكر السفر
أعلنت الخطوط الجوية القطرية أحدث عروضها على تذاكر رحلات الطيران للدرجة السياحية من الدوحة، إلى وجهات عربية وغربية، في أوقات محددة. وتشمل العروض...
18652
| 06 يونيو 2026
- 3 قرار لوزيرة التعليم بشأن تحديد ثمن الكتب الدراسية وأجرة المواصلات من الطلبة غير القطريين والإعفاء منها
نشرت الجريدة الرسمية في عددها التاسع لسنة 2026 الصادر اليوم الأحد، قرار وزير التربية والتعليم والتعليم العالي رقم (5) لسنة 2026 بتعديل بعض...
17304
| 07 يونيو 2026



